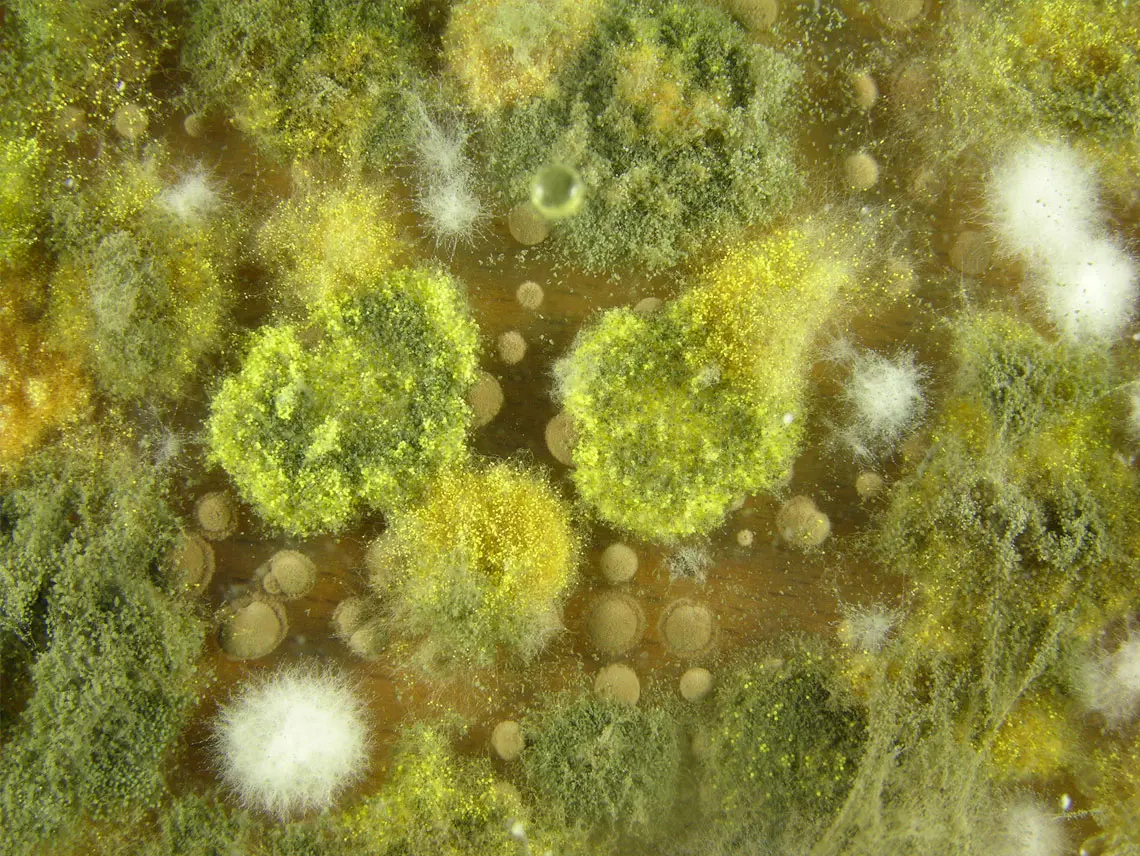

Schimmelanalyse und Prävention
Die Grundlage einer effektiven Schimmelsanierung und -prävention bildet eine umfassende Schimmelpilzanalyse mit anschließender Ursachenbestimmung.
Als Schimmelsachverständiger bieten wir nicht nur fundierte Analysen, sondern erstellen auch ein gesichertes Gutachten.
Sobald die Ursachen des Befalls identifiziert wurden, informieren wir Sie ausführlich über den Befund, erläutern präventive Maßnahmen und präsentieren Ihnen ein maßgeschneidertes Sanierungskonzept.
Warum Swiss Renovation?
Kontaktieren Sie uns noch heute für Ihre professionelle Schimmelanalyse!
Lassen Sie sich individuell beraten und starten Sie in ein schimmelfreies Zuhause.
Fachwissen
Experten für LösungenProfessionelle
Höchste Qualität bei Planung und Ausführung, Termintreue und professionelle Koordination aller Gewerke
Gesundheit
Minimierung von Gesundheitsrisiken.Gesundheitsschutz
Einsatz staubarmer Verfahren und schonender Materialien zur Minimierung von Gesundheitsrisiken.
Nachhaltigkeit
Innovative TechnikenNachhaltigkeit
Nachhaltige Lösungen zur Verbesserung des Wohnkomforts und zur Reduzierung des CO2-Ausstoßes